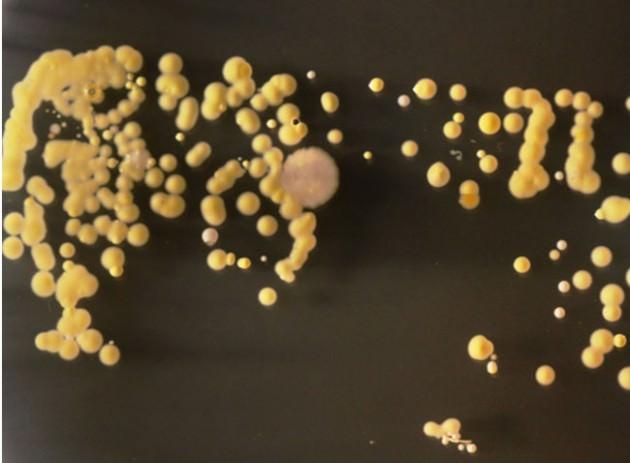
Öğrenciler, bakterileri laboratuvarlarda ürettiler ve geliştirdiler. Cep telefonunu bakteri üretme kaplarına koyan öğrenciler, 3 gün sonra bu garip yaratıkları görüntülediler.

Cep telefonunda yaşayan canlılar
27.02.2013
15:15
Öğrenciler, bakterileri laboratuvarlarda ürettiler ve geliştirdiler. Cep telefonunu bakteri üretme kaplarına koyan öğrenciler, 3 gün sonra bu garip yaratıkları görüntülediler.